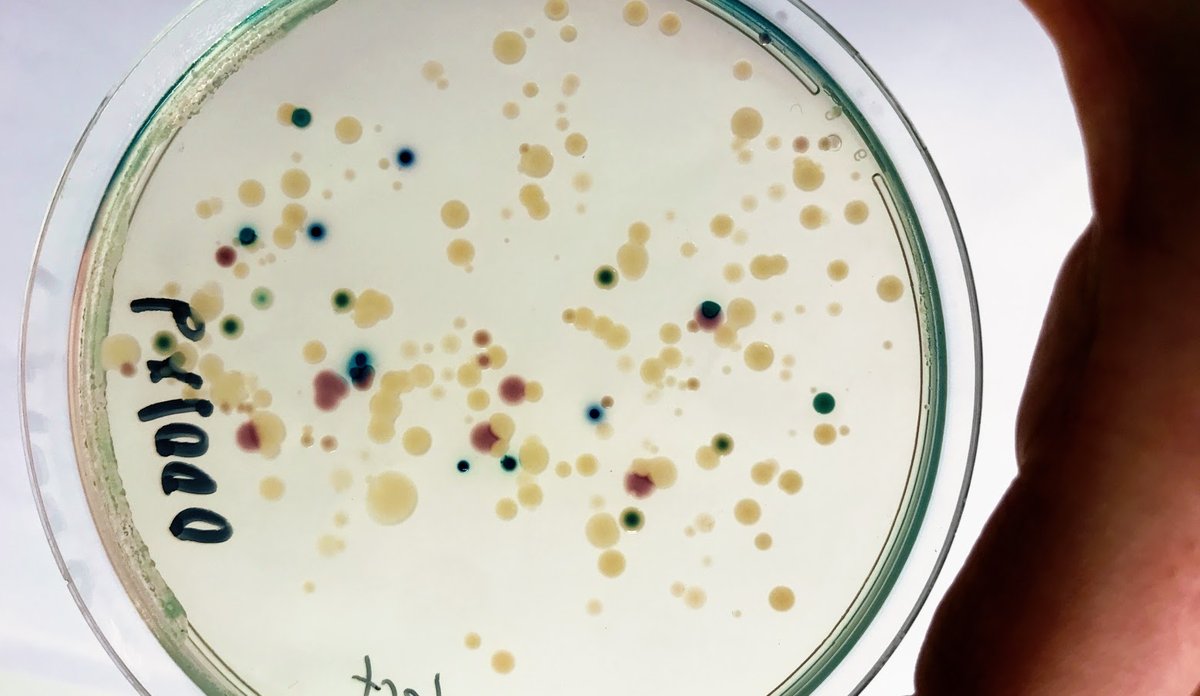
vibrio

Badetemperaturane stig: Forskarane ser etter kjøtetande bakteriar
Forskarane dyrkar fram kulturar av isolerte vibrio-bakteriar.
Fotograf: Cecilie Smith Svanevik / HIPublisert: 06.07.2020
– No som vi går inn i sommaren med høge badetemperaturar, kjem vi til å ta jamlege prøvar av blåskjel for å sjå etter Vibrio-bakteriar, fortel havforskar Cecilie Svanevik.
Kan gi magesjau eller hudinfeksjon
Vibrio lever naturleg i sjøen. Det er mange ulike typar av dei. Nokre er harmlause, nokre gir matforgifting og andre kan angripe sår hos badegjestar.
– Sår som er infisert med kjøtetande Vibrio kan i dei verste tilfella ende med amputering, fortel Svanevik.
I fjor blei vibrioinfeksjonar meldepliktige – og det var 30 tilfelle mellom juni og august. Truleg knytt til bading.
Bonus frå blåskjelvarselet
– Når vi tar prøver av blåskjel, kjem vi først og fremst til å få svar på om dei er trygge å ete, trass dei høge vanntemperaturane. Samtidig vil det seie noko om kor mykje sjukdomsframkallande Vibrio det er i sjøen elles, seier Svanevik.
Sidan blåskjell lever av å filtrere sjøvatn for partiklar, kan dei samle opp mykje rart. I den faste blåskjelovervakinga HI gjer på vegner av Mattilsynet (Blåskjelvarselet), ser vi etter giftige algar og tarmbakteriar, som kan bety at det er kloakk på ferde. Det er dei same skjela forskarane no vil sjekke for Vibrio.

Bakterien toler varmebehandling dårleg. Så for mattryggleiken er ikkje Vibrio noko problem om du kokar skjela.
– Det er ikkje på plass god overvaking av sjukdomsframkallande Vibrio i dag, så dette blir eit første forsøk, seier Svanevik.
FHI gir også baderåd
Svanevik og forskarkollegaar har nettopp publisert ein studie der dei såg etter Vibrio og antibiotikaresistens i Norge mens vanntemperaturane var låge. Då fann dei få bakteriar som kunne gi sjukdom, og få teikn til resistens.
Det europeiske smittevernsenteret har eit kart over kor det er trivselstemperatur for Vibrio i sjøen. Det dekker til og med søraust-Norge og ser slik ut i veke 27:
Folkehelseinstituttet har eigne forholdsreglar mot Vibrio ved bading: fhi.no/ml/badevann/bakterier-i-sjovann-kan-gi-infeksjoner
I andre land har bakteriane blitt resistente mot antibiotika
Land med varmare kystvatn har større utfordringar med at Vibrio trivst godt. I område med høgt antibiotikaforbruk kan også bakteriane ha utvikla resistens mot antibiotika. Då kan infeksjonar vere skikkeleg skumle.
– Restriktiv bruk av antibiotika i Norge kan vere ei årsak til at vi finn lite resistent Vibrio i Norske farvatn. Slik håpar vi det held seg, seier ho.
Referanse
Håkonsholm, Fredrik, Bjørn Tore Lunestad, Jose Roberto Aguirre Sánchez, Jaime Martinez‐Urtaza, Nachiket Prakash Marathe, og Cecilie Smith Svanevik. "Vibrios from the Norwegian marine environment: Characterization of associated antibiotic resistance and virulence genes." MicrobiologyOpen: e1093. Lenke: https://doi.org/10.1002/mbo3.1093
